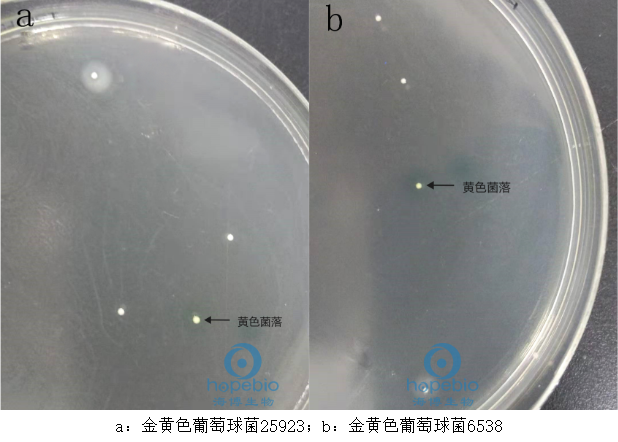
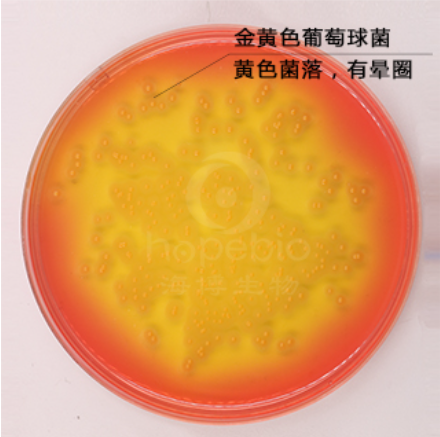
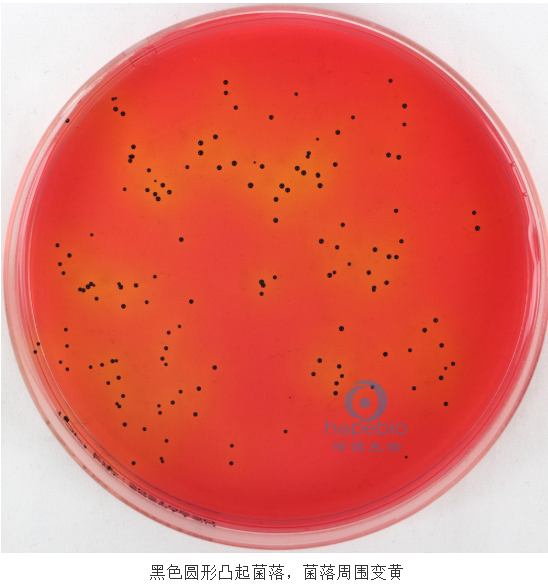

海博微信公众号
海博微信公众号
 海博天猫旗舰店
海博天猫旗舰店


 海博微信公众号
海博微信公众号
 海博天猫旗舰店
海博天猫旗舰店




一、金黄色葡萄球菌简介
金黄色葡萄球菌(Staphylococcus aureus,S. aureus),隶属于葡萄球菌属,是革兰氏阳性菌代表,为一种常见的食源性致病微生物。金黄色葡萄球菌对高温有一定的耐受能力,在80℃以上的高温环境下30min才可以将其彻底杀死,另外金黄色葡萄球菌可以存活于高盐环境,最高可以耐受15%浓度的NaCl溶液。由于细菌本身结构特点,利用70%的乙醇可以在几分钟之内将其快速杀死。金黄色葡萄球菌代谢类型为需氧或兼性厌氧,对环境要求不高,37℃为最适生长温度,能在各种恶劣环境中存活下来。
金黄色葡萄球菌是常见的食源性致病菌,常寄生于人和动物的皮肤、鼻腔、咽喉、肠胃、痈、化脓疮口中,空气、污水等环境中也无处不在。金黄色葡萄球菌 在适当的条件下,能够产生肠毒素,引起食物中毒。金黄色葡萄球菌引发的食物中毒报道层出不穷,由金黄色葡萄球菌引起的食物中毒占食源性微生物食物中毒事件的25%左右,金黄色葡萄球菌成为仅次于沙门氏菌和副溶血杆菌的第三大微生物致病菌。
二、金黄色葡萄球菌常用的分离培养基
1、Baird-Parker琼脂基础
(1)检验原理
胰蛋白胨、牛肉浸粉和酵母浸粉提供碳氮源、维生素和生长因子;丙酮酸钠和甘氨酸刺激葡萄球菌的生长;氯化锂抑制非葡萄球菌的微生物;含有卵磷脂酶的葡萄球菌降解卵黄使菌落产生透明圈,而脂酶作用则产生不透明的沉淀环;凝固酶阳性的葡萄球菌还能还原亚碲酸钾而产生黑色菌落;琼脂是培养基的凝固剂。
添加剂:每瓶需配套添加5盒HB4116-1亚碲酸盐卵黄增菌液使用,每95mL Baird-Parker琼脂基础中添加1支。
(2)产品配制方法
称取本品63.0g,加热溶解于950mL蒸馏水中,分装每瓶95mL,121℃高压灭菌15min,临用前加热溶化琼脂,冷至50℃左右,于每95 mL培养基中加入常温解冻的亚碲酸钾卵黄增菌剂5 mL摇匀后倾入无菌平皿。
(3)在36℃±1℃需氧培养45h-48h,金黄色葡萄球菌的单个菌落呈圆形,表面光滑、凸起、湿润,直径2mm-3mm。灰黑色至黑色,有光泽,常有浅色(非白色)的边缘,周围绕以不透明圈(沉淀),其外常有一清晰带。

图1 金黄色葡萄球菌在Baird-Parker琼脂平板上的菌落特征
2、葡萄球菌选择性琼脂培养基110号
(1)检验原理
胰酪蛋白胨、酵母浸粉提供微生物生长所需的碳氮源、维生素和氨基酸;D-甘露醇为可发酵的糖类;乳糖为金黄色葡萄球菌可利用的糖类;氯化钠用以维持反应体系的渗透压;磷酸氢二钾是缓冲剂;琼脂作用是培养基凝固剂。
甘露醇发酵产酸试验:金黄色葡萄球菌可利用甘露醇产酸,溴麝香草酚蓝指示剂为pH指示剂(变色范围为pH值6.0~7.6),在酸性条件下显黄色,即溴麝香草酚蓝指示剂使金黄色葡萄球菌显示阳性结果。
明胶液化试验:金黄色葡萄球菌能产生明胶酶,使明胶分解为氨基酸,从而失去凝固力,即显示阳性结果。
(2)产品配制方法
称取本品149.5g,加热溶解于1000mL蒸馏水中,121℃高压灭菌15min,备用。
(3)金黄色葡萄球菌在葡萄球菌选择性琼脂培养基110号上,36℃±1℃培养24h-48h,生长良好;甘露醇发酵产酸试验:用0.04%溴麝香草酚蓝指示剂滴加于菌落,变为黄色,为阳性;明胶液化试验:将硫酸铵饱和水溶液滴加于菌落,10min后,围绕菌落出现一清晰带,为阳性。

图2 金黄色葡萄球菌在葡萄球菌选择性琼脂培养基110号平板上的菌落特征
3、甘露醇卵黄培养基基础
(1)检验原理
蛋白胨和牛肉粉提供氮源、维生素和生长因子;D-甘露醇为可发酵糖类;氯化钠可抑制除葡萄球菌外的大部分微生物的生长;琼脂是培养基的凝固剂;酚红为pH指示剂,金黄色葡萄球菌可分解培养基中的甘露醇产酸,使菌落周围变黄,并能降解卵黄中的卵磷脂使菌落产生晕圈。
添加剂:每瓶需配套添加6盒HB8295 50%卵黄乳液使用,每支添加于166mL甘露醇卵黄培养基基础。
(2)产品配制方法
称取本品112.5g,加热溶解于1000mL蒸馏水中,煮沸1min,121℃高压灭菌15min,冷却至45℃-50℃时,无菌操作加入50%卵黄乳液30mL,摇匀,倾入无菌平皿。
(3)金黄色葡萄球菌在甘露醇卵黄培养基平板上,36℃±1℃需氧培养24h-48h,典型菌落特征为黄色菌落,菌落周围有晕圈。
图3 金黄色葡萄球菌在甘露醇卵黄培养基平板上的菌落特征
4、TMP琼脂培养基
(1)检验原理
蛋白胨、酵母浸粉提供基本的营养;高浓度的氯化钠具有选择性,可抑制部分不耐盐细菌的生长;甘露醇为可发酵糖类;磷酸氢二钾为pH缓冲剂;苯酚红为酸碱指示剂;琼脂为凝固剂;较高浓度的亚碲酸钾可抑制多数杂菌的生长,并可被金黄色葡萄球菌还原,菌落呈黑色。金黄色葡萄球菌具有较强的耐盐性,可在此培养基中生长,并还原亚碲酸钾,菌落显黑色,同时可分解培养基中的甘露醇产酸,使培养基变黄。
添加剂:每瓶需配套添加1盒HB0123 1%亚碲酸钾溶液使用。
(2)产品配制方法
称取本品90.0g,加热溶解于1000mL蒸馏水中,121℃高压灭菌15min,冷至50℃左右时,加入无菌1%亚碲酸钾溶液15mL,混匀,倾入无菌平皿,备用。
(3)金黄色葡萄球菌在TMP琼脂培养基平板上,36℃±1℃需氧培养24h-48h,典型菌落特征为黑色圆形凸起菌落,菌落周围变黄。
图4 金黄色葡萄球菌在TMP琼脂培养基平板上的菌落特征
5、豆粉琼脂
(1)检验原理
牛心浸粉、豌豆浸粉提供碳氮源、维生素和生长因子;氯化钠维持细菌平衡的渗透压;琼脂是凝固剂。
添加剂:每瓶需配套添加1001339-1脱纤维羊血使用。
(2)产品配制方法
称取本品3.8g,加热溶解于100mL蒸馏水中,121℃高压灭菌15min,冷至50℃-55℃时无菌操作加入5%-10%(V/V)预温至37℃的无菌脱纤维羊血,混匀,倾入无菌平皿。
(3)金黄色葡萄球菌在豆粉琼脂平板上,36℃±1℃需氧培养18h-24h,典型菌落特征为菌落周围产生β溶血环。

图5 金黄色葡萄球菌在豆粉琼脂脂平板上的菌落特征
6、甘露醇高盐琼脂
(1)检验原理
蛋白胨和牛肉粉提供氮源、维生素和生长因子;D-甘露醇为可发酵糖类;7.5%浓度氯化钠可抑制除葡萄球菌外的大部分微生物的生长;琼脂是培养基的凝固剂;酚红为pH指示剂。
(2)产品配制方法
称取本品109.0g,加入1000mL蒸馏水中,加热溶解并不停搅拌煮沸1min。121℃高压灭菌15min,冷至45℃-50℃左右时,倾入无菌平皿。
(3)金黄色葡萄球菌在甘露醇高盐琼脂平板上,36℃±1℃需氧培养24h-48h,典型菌落特征为黄色菌落,菌落周围黄色。

图6 金黄色葡萄球菌在甘露醇高盐琼脂平板上的菌落特征
7、却普曼琼脂
(1)检验原理
蛋白胨、酵母浸粉提供细菌生长所需的基本营养,磷酸氢二钾为缓冲剂,甘露醇为可发酵碳源,较高浓度的氯化钠可抑制不耐盐细菌的生长,高浓度的硫酸铵可使明胶发生沉淀析出,培养基呈不透明状。金黄色葡萄球菌可耐高渗环境,能在此培养基中生长,将不溶性大分子的明胶分解为小分子可溶性的氨基酸,菌落周围的培养基变为透明状。金黄色葡萄球菌还可分解培养基中的甘露醇产酸,培养结束后,滴加酸碱指示剂可观察产酸现象。
(2)产品配制方法
称取本品202.5g,加热溶解于1000mL蒸馏水中,分装,121℃高压灭菌15min,冷至45℃-50℃时,倾入无菌平皿,备用。
(3)金黄色葡萄球菌在却普曼琼脂平板上36℃±1℃需氧培养24h-48h,在除去菌落的琼脂表面,加一滴0.04%溴甲酚紫,变为黄色,能发酵甘露醇为阳性。


图7 金黄色葡萄球菌在却普曼琼脂平板上的菌落特征
8、甘露醇氯化钠琼脂培养基(中国药典)
(1)检验原理
胨和牛肉浸出粉提供碳源、氮源、维生素和矿物质;D-甘露醇为可发酵的糖类;较高含量的氯化钠提供较高的渗透压,抑制大多数非葡萄球菌的微生物;酚红为pH指示剂;琼脂是培养基的凝固剂。典型致病性葡萄球菌(凝固酶阳性)发酵D-甘露醇产酸而产生黄色带有黄晕的菌落,典型非致病性葡萄球菌不发酵D-甘露醇而形成红色菌落。
(2)产品配制方法
称取本品111.0g,加入1000mL纯化水中,加热溶解并不停搅拌煮沸1min。121℃高压灭菌15min,冷至45℃-50℃左右时,倾入无菌平皿。
(3)金黄色葡萄球菌在甘露醇氯化钠琼脂培养基平板上,30℃-35℃需氧培养18h-72h,典型菌落特征为黄色菌落,周围有黄色环。

图8 金黄色葡萄球菌在甘露醇氯化钠琼脂培养基平板上的菌落特征
三、产品展示
我公司有多种金黄色葡萄球菌检测的培养基,客户可根据实际应用情况和用途进行选用。
表1 部分产品信息
|
产品货号 |
产品名称 |
规格 |
用途 |
|
HB4115 |
250g/瓶 |
用于金黄色葡萄球菌的选择性分离培养(GB、FDA、ISO、SN标准) |
|
|
HB4123-1 |
250g/瓶 |
用于金黄色葡萄球菌的分离培养 |
|
|
HB4125 |
250g/瓶 |
用于分离培养病原性金黄色葡萄球菌(日本标准) |
|
|
HB4152 |
250g/瓶 |
用于金黄色葡萄球菌的分离培养 |
|
|
HB6242 |
250g/瓶 |
用于分离营养要求较高的致病菌 |
|
|
HB4128 |
250g/瓶 |
用于金黄色葡萄球菌的选择性分离培养 |
|
|
HB8644 |
250g/瓶 |
用于检测金黄色葡萄球菌 |
|
|
HB4128-22 |
250g/瓶 |
用于金黄色葡萄球菌的选择性分离培养 |
注:本文属海博生物原创,未经允许不得转载。
上一篇:卵磷脂在培养基中的作用机制和应用
下一篇:自然界中常见的嗜酸性细菌
| 相关文章: | ||



